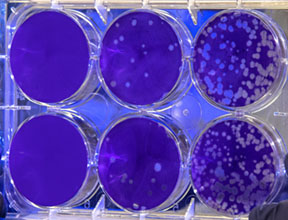
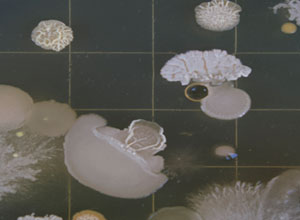

Cell Model and Evaluation Core
Cell Model and Evaluation Core provides expertise, training, resources, and specialized equipment in three areas: procure, grow, and distribute well-differentiated primary human airway epithelial cells from CF and non-CF donors.

Animal and Preclinical Models Core
Animal and Preclinical Models Core serves to provide specialized capabilities for developing and characterizing numerous CF animal models relevant to CF pathogenesis and treatment.

Clinical and Translational Core
The Clinical and Translational Core provides necessary resources and expertise to provide these capabilities for a wide variety of CF scientists, significantly improving the ability to identify and translate CF scientific advances to new therapeutics.

Functional Assay Core
Functional Assay Core provides investigators with training, expertise and specialized equipment to aid in the advancement of basic and translational science studies in CF in these model systems.

Gene Expression Core
The Gene Expression Core was founded in 1994 and promotes translational, multidisciplinary CF research by furnishing expertise concerning recombinant CFTR and other proteins relevant to CF disease mechanism.

CFTR Rat Models Core
CFTR Rat Models Core is designed to fulfill two key functions:
- Breed, genotype, and distribute diverse CF rat models and tissues.
- Conduct and develop endpoint measures to assess CFTR function, epithelial physiology, preclinical endpoints, and biospecimen analysis in CF rat models, with and without chronic lung infection

CFTR Protein Production Core
The CFTR Protein Distribution Core offers high-quality, full-length recombinant cystic fibrosis transmembrane conductance regulator (CFTR) proteins expressed in and purified from mammalian cells.
The Animal Physiology Core (APC) provides for diabetes related phenotyping in small animal models. Services offered include the assessment of body composition, energy balance, glucose homeostasis, cardiovascular assessment, imaging, and transgenic animals models.
Aquatic Animal Research Core (AARC) to facilitate research using important aquatic animal models, including zebrafish and killifish. Recent reviews support the utility of these models in biomedical research related to nutrition and obesity.
This core provides state-of-the-art instrumentation and methodology for the determination of energy balance and body composition in small animals.
Tree shrews are more closely related to humans than are mice and rats, studies in tree shrews have an increased likelihood of providing information that can be translated to humans.
The Behavioral Assessment Core provides a facility for the behavioral testing of mice and rats. Newly created transgenic mice can be analysed using the most-accepted battery of behavioral tests, the SHIRPA (Rogers et al. 1997).
he Transgenic & Genetically Engineered Models (TGEMs) Core Facility provides a variety of services to the UAB community and partner institutions.
CCTS Informatics provides investigators with access to clinical data for research via (1) our self-service i2b2 tool or (2) an Electronic Data Warehouse (EDW) analyst.
The general purpose of the Cell Senescence Culture Facility (CSCF) is to provide various types of aging cells to investigators interested in the aging process.
The UAB Comparative Pathology Laboratory (CPL) supports the Animal Resources Program (ARP) animal care and health surveillance programs, and assists UAB investigators in achieving their specialized animal research objectives.
he Cryo-Electron Microscopy Facility provides capabilities for high-resolution electron microscopy and tomography of stained and unstained specimens.
The UAB Gregory Fleming James Cystic Fibrosis Research Center is a university-wide interdisciplinary research center funded by the National Institutes of Health, the Cystic Fibrosis Foundation, and institutional resources dedicated to fostering an innovative, multidisciplinary environment to pursue, advance, and train in cystic fibrosis-related science.
The Mission of the Experimental Biomechanics Core (EBC) is to provide collaborating investigators with state-of-the-art equipment and trained personnel to facilitate mechanical testing and measurement of mechanical properties of biological and man-made materials, structures, and constructs.
The primary purpose of both the Ocular Phenotyping and Molecular & Celluar Analysis Cores is to support vision research at UAB.
The mission of the Core Laboratory is to assist in the identification and characterization of protein interactions without the need to establish various methodologies in individual laboratories.
Aquatic Animal Research Core (AARC) to facilitate research using important aquatic animal models, including zebrafish and killifish. Recent reviews support the utility of these models in biomedical research related to nutrition and obesity.
Patient Navigation began as a pilot project called Community Health Advisors in Action Program (CHAAP), funded by the Avon Foundation, under principal investigator Mona Fouad, MD, MPH.
UCEM's ECTF is a 7000 square feet core facility that is well-equipped to provide a clean, safe, and user friendly exercise training and testing environment for supervised exercise clinical trials.
The Molecular Detection Core (MDC) Laboratory is designed to provide sensitive immunohistochemical (IHC) and in situ hybridization (ISH) assistance to the UAB Neuroscience community.
We support shared core facilities to enhance collaborations and further research in kidney-related research, foster interactions among investigators from different backgrounds and disciplines whose shared interest is in kidney research, and provide intellectual resources and infrastructure to attract new and established investigators to AKI research.
The Instrumentation Core provides the VSRC members with assistance in design and fabrication of equipment and new research instruments including analog/digital devices and other custom equipment required to successfully conduct research.

NORC Animal Physiology Core

NORC Aquatic Animals Core

Small Animal Phenotyping Core

Tree Shrew Core

Behavioral Assessment Core

UAB Transgenic & Genetically Engineered Models Core (TGEMs)

Research Implementation

Cell Senescence Culture Facility

Comparative Pathology Laboratory

Cryo-Electron Microscopy Facility

Cystic Fibrosis Research Center

Experimental Biomechanics Core
Molecular and Cellular Analysis Core

Neuroscience Vector and Virus Core

Pathology Core Research Lab

Patient Navigation Services

UAB Center for Exercise Medicine

UAB Neuroscience Molecular Detection Core

UAB-UCSD O'Brien Core Center for Acute Kidney Injury Research

VSRC Instrumentation Core
Biostatistics, Epidemiology and Research Design team collaborates with investigators at any stage, from student to senior faculty, across the CCTS Partner Network, pairing expertise with study-specific needs and providing state-of-the-art study design, data management, and statistical analysis.
Bionutrition Unit offers a variety of services to investigators in nutrition-related research. Dietitians are available to help plan, design, and implement the nutritional components of research protocols; recruit and screen research participants; and collect and analyze dietary intake data.
Clinical Research Support Program (CRSP) unit offers flexible, cost-effective services to research teams across the lifecycle of a clinical study.
Nursing Services of the Clinical Research Unit facilitate research through the delivery of expert nursing care and by providing resources necessary to assist the principal investigator in the successful completion of their research study.
Research Commons domain connects investigators to the expertise and technology they need, including to inter-institutional resources, consultations, and collaborators across our Partner Network.
The CCTS SPAN and Biorepository specializes in research based clinical specimen processing and specimen biobanking with barcoded inventory management in OnCore.

Biostatistics, Epidemiology and Research Design (BERD)

Bionutrition Core

Clinical Research Support Program

Clinical Research Unit Nursing

Research Commons

Specimen Processing and Biorepository Unit

UAB Informatics
CCTS Informatics provides the resources and expertise (both bioinformatics and clinical informatics) to support biomedical collaboration and consultation across the translational research spectrum.

Big Data Analytics
Big Data Analytics work on scalability, parallel computing, grid computing, cloud computing, data mining, text mining, information fusion, data visualization, and big data analytics for forensics, cybercrime, cyberbullying, and biomedical applications.

Geospatial Mapping, Analysis, and Data
The Geospatial Mapping, Analysis, and Data (GeoMAD) Unit is a service unit developed by the UAB Center for the Study of Community Health.

CFAR Biostatistics and Analysis Services
The CFAR Biostatistics and Analysis Services, a component of the Clinical Core, provide statistical, epidemiologic, health services research and bioinformatics support to CFAR investigators for the development of research proposals including data management and quality control with analyses.

Biostatistics and Bioinformatics Shared Facility (BBSF)
The primary objective of the Biostatistics and Bioinformatics Shared Facility is to provide centralized statistical services and collaborative research support for the research projects of the Cancer Center.

Survey Research Unit (SRU)
The Survey Research Unit conducts approximately 40,000 surveys annually for UAB investigators, local and state health departments, and other state and national agencies.

NORC Biostatistics Core
NORC Biostatistics efforts incorporate creativity in experimental designs and statistical consultation, support statistical training, and incorporate novel statistical approaches into the dynamic nutrition and obesity research conducted at UAB

Central Alabama High-Field NMR Facility
Central Alabama High-Field NMR Facility is an essential university-wide resource dedicated to supporting structural biology and drug discovery, and to making this powerful analytical technique available to researchers throughout UAB and elsewhere in the scientific community.

Visual Brain Core
CINL Brain Core is an arm of the Civitan International Neuroimaging Laboratory

UAB Center for AIDS Research Clinical Core
Clinical Core provide easy access to comprehensive clinical services, resources and expertise supporting basic science, behavioral, epidemiological, translational, clinical and public health research.

Recruitment and Retention Shared Facility (RRSF)
The Recruitment and Retention Shared Facility team includes data managers and analysts, project planners and coordinators, telephone interviewers, and community outreach personnel.

VSRC Research Programming & Computational Analysis Core
The main goal of the Research Programming & Computational Analysis Core is to provide assistance in configuring software and hardware to ensure that computer equipment meets all requirements for proper execution of vision science experiments and other research related activities.

Behavioral and Community Sciences Core
The CFAR Behavioral and Community Sciences Core offers services to UAB researchers and community partners who are conducting, or who are interested in conducting, behavioral and community science studies in the areas of HIV prevention and treatment.

Evaluation and Assessment Unit (EAU)
The Evaluation and Assessment Unit (EAU) exists to provide evaluation and assessment services both within and outside of the UAB Center for the Study of Community Health; across UAB’s Campus, and on projects with partnering organizations outside of the academic setting.

UAB Kinome Core
Kinomics is the study of the kinome, a global description of kinases and kinase signaling. Since kinases drive numerous signaling pathways in biology (both normal and disease), determining the pertinent kinases in a biological system is of high importance.

Multidisciplinary Molecular Interaction Core (MMIC)
The Multidisciplinary Molecular Interaction Core (MMIC) provides use of a Biacore T200 biosensor that is capable of determining the binding kinetics, specificities, and thermodynamics of biomolecular interactions.

UAB Nanostring Laboratory
Nanostring platform enables the profiling of hundreds of targets simultaneously with high sensitivity and precision, even in formalin fixed paraffin embedded (FFPE) tissues, without the need for amplification steps except in single cell or low cell number experiments.

Nanoscale Materials Fabrication and Characterization Core
The Nanoscale Materials Fabrication and Characterization Core in the UAB Center for Nanoscale Materials and Biointegration (CNMB) feature state of the art nanofabrication and characterization facilities.

Civitan Neurodevelopmental Bioinformatics Initiative
The Neurodevelopmental Bioinformatics Initiative (NBI) seeks to aid the UAB neuroscience community in the design and analysis of high-throughput genomic studies to advance Civitan's mission to expand our knowledge of neurodevelopmental and intellectual disabilities.

CFAR Virology Core
The Virology Facility has evolved around two primary activities:
- The provision of campus-wide laboratory infrastructure for BSL2+ research.
- The provision of services that facilitate the research adapted to the needs of our CFAR members.

BioAnalytical Redox Biology (BARB)
The BioAnalytical Redox Biology provides state-of-the-art services in mitochondrial damage, function, proteomics, and oxidative stress assessment support for investigators carrying out diabetes mellitus (DM) and cardiometabolic disease (CMD) research at UAB.

Interventions & Translational Core
The Interventions and Translational Core (ITC) is a major focus of prevention and control research in diabetes and cardiometabolic disease both at UAB and at the national level.

NORC Physical Activity Core
Obesity, energetics, and diabetes are major priority areas in the strategic plans of multiple units, and UAB makes major investments in these areas.

Alabama Acute Care Research Team
Alabama Resuscitation Center is the UAB Department of Emergency Medicine is a national leader in emergency and acute care research.
CCTS Auburn University MRI Research Center
Our vision is to leverage Auburn University's existing expertise in engineering, sciences, and veterinary medicine to improve healthcare through advanced magnetic resonance imaging.

CCTS Partner Network
The CCTS Partner Network crosses institutional boundaries to improve human health and health care delivery. This innovative partnership provides the foundation for addressing health disparities through collaborative research and training efforts.

CCTS Partner Network - Tuskegee University
Tuskegee University’s area of investigative expertise is their National Center for Bioethics in Research and Health Care.

CCTS Training Academy
The National Center for Advancing Clinical and Translational Science (NCATS), our Training Academy domain offers interdisciplinary, educational programs and enrichment activities for research teams across the academic career arc– from graduate and postgraduate students to junior and senior faculty.

Division of Continuing Medical Education
A new CME program is available on psoriatic arthritis featuring UAB's own Dr. Laura Hughes, Professor of Medicine in the Division of Clinical Immunology and Rheumatology.

Genifx Genome Informatics Service
Genome Informatics. We provide software and hardware infrastructure to store and analyze NextGeneration (NGS) sequence data.

Intercampus Interactive Telepresence System
The UA System's Intercampus Interactive Telepresence System (IITS) is a statewide videoconferencing network. IITS connects users to in-state, national and international conferencing, course instruction, research endeavors and meeting participation.

Service Center for Clinical Rehabilitation Assessment and Intervention
The Center for Engagement in Disability Health and Rehabilitation Science to address the health, wellness and rehabilitation needs of millions of Americans with disabilities who have substantially higher rates of health disparities, secondary health conditions and health care utilization compared to the general population.

Targeted Metabolomics and Proteomics Laboratory
The Targeted Metabolomics and Proteomics Laboratory (TMPL) is organized to provide a variety of analytical and technical services using mass spectrometry to UAB investigators.

Tissue Collection and Banking Facility
UAB Tissue Biorepository (UAB-TBR), formerly known as the UAB Tissue Collection and Banking Facility, is to collect, process, store, and distribute high quality human tissue specimens to investigators of UAB, members.

UAB Cyclotron Facility
UAB's new T24 cyclotron is an extraordinary machine, the most powerful of any in an academic medical center in the United States. UAB's cyclotron has been strategically positioned on campus, with its 30-ton weight factor, furthering its reputation of being the most powerful cyclotron at any academic medical center in the United States.

UAB IT Research Computing Services
UAB IT Research Computing provides comprehensive support for researchers that use Cheaha, the campus high performance compute cluster. Research computing staff develop and maintain the cluster and provide advanced software and consulting support if needed by researchers.

UAB Libraries
UAB Libraries (www.uab.edu/libraries) hold more than two million volumes and provide access to thousands of relevant digital resources for information, instruction, and research in support of UAB’s vast academic and medical enterprise.

University of Alabama Central Analytical Facility
The mission of the Central Analytical Facility is to enable and facilitate collaborative, multi-investigator, multi-disciplinary, multi-campus and regional research involving major research instrumentation.

Zebrafish Research Facility
The zebrafish (Danio rerio) has become an important model organism for the study of vertebrate development and disease, organ function, behavior, toxicology, cancer, and drug discovery.